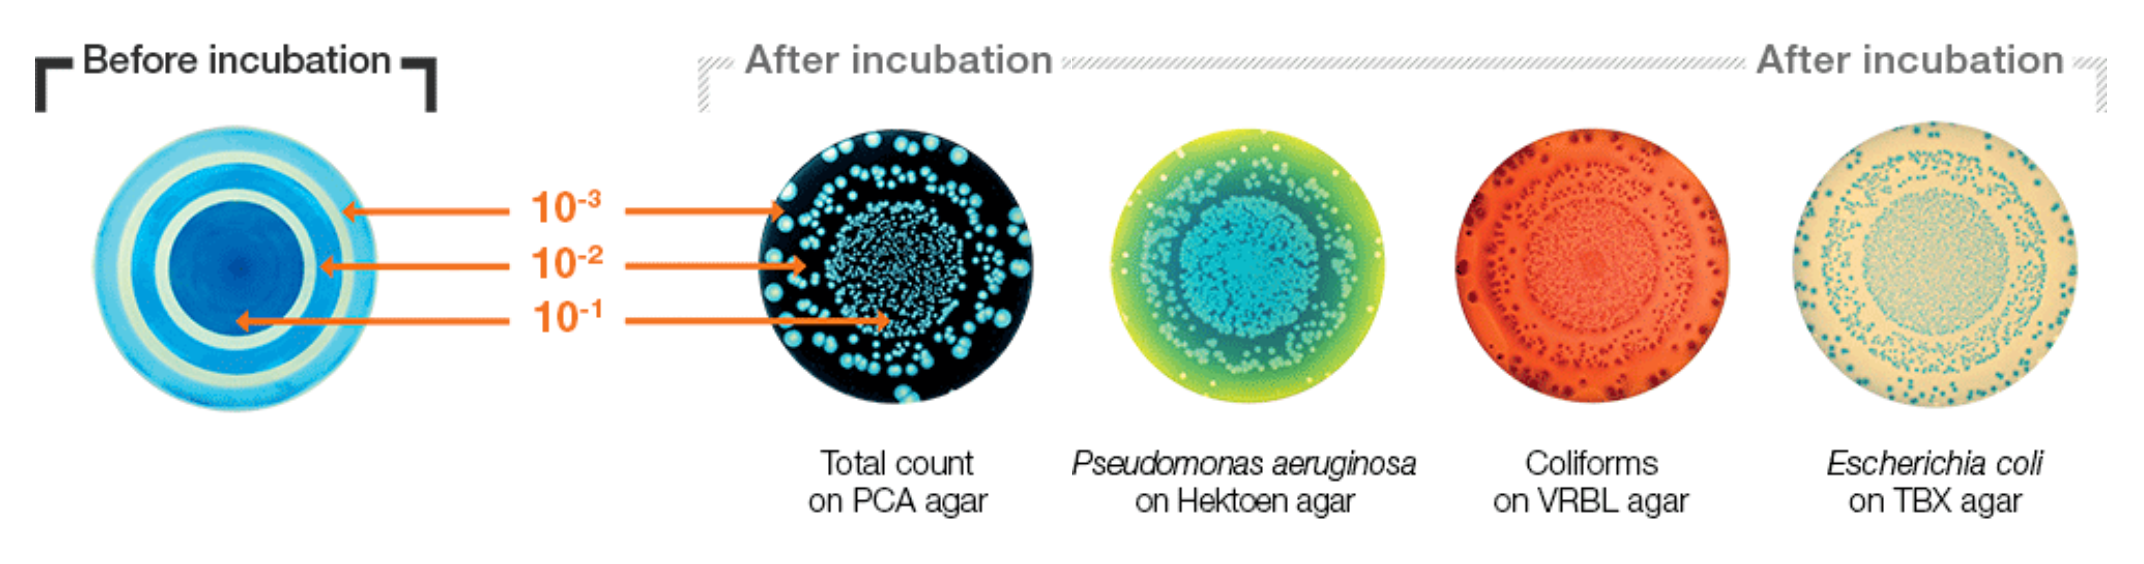

easySpiral dilute
Automatic dilutor and plater
Plater and dilution features
easySpiral Dilute is an automatic diluter and plater of Petri dishes. It allows 1/10th serial dilutions and plating up to 6 log. dilution on 1 single Petri dish. For a sample of 30 to 1 x 1012 bacteria, no more manual dilutions and plating is automatic.
- Automatic cycle of 5 successive dilutions at 1/10th
- Plating modes: exponential, constant, circle, pour plate
- Counting range: from 30 to 1x1012 CFU/mL
- Plating cycle time: 134 seconds
A revolution for your serial dilutions!
You no longer need to prepare 9 mL tubes, easySpiral Dilute automatizes serial dilutions to 10-5 or more.
Place the sample
Place your sample in a beaker and choose your dilution factor: from 10-1 to 10-5
Dilute automatically
EasySpiral Dilute automatically dilutes the sample up to 5 times.
Plate automatically
EasySpiral Dilute plates a sample on 1 Petri dish from 30 to 1x1012 CFU/mL
The Spiral method
With the Spiral method, increase your analysis capabilities: without intermediate dilutions, perform standardized automatic plating with a counting range from 100 to 1 x 107 CFU/mL on 1 single Petri dish!
50% time-saving and consumables savings
EasySpiral Dilute saves you 50% in consumables and 50% in time. 134 seconds for plating (1 disinfection + 5 dilutions + 1 plating of a dilution). Example on 50 samples with
a 10-7 dilution and a 10-5, 10-6 and 10-7 plating

One touch plating
Plate easily and quickly your 90 and 150 mm Petri dishes. Choose from 3 plating modes: exponential, constant and circle.

Exponential mode
The exponential mode is a plating in surface with a decreasing surface concentration. Plate 50 µL, 100 µL, 200 µL or program a customizable volume. Obtain a countable Petri dish from 100 to 1 x 1012 CFU/mL

Constant mode
The exponential mode is a plating in surface with a decreasing surface concentration. Plate 50 µL, 100 µL, 200 µL or program a customizable volume. Obtain a countable Petri dish from 100 to 1 x 1012 CFU/mL
Circle mode
The circle mode is plating 3 or 6 dilutions in surface on 1 Petri dish. The volumes are 10 µL for the inner circle, 16 µL for the middle circle and 25 µL for the outer circle. Great savings on Petri dishes!

Pour mode
The pour mode is a homogeneous deposition in pour plate mode. easySpiral Dilute deposits one sample drop at the bottom of an empty Petri dish. Then the user adds the molten agar on top and homogenizes it with the sample. You can plate 50 µL, 100 µL, 200 µL or program your personalized volume. Colony counting is easier in case of invasive colonies. Pharmacopea compliant.

High speed automation
The fast rotating arm adapts itself to all types of agar without risks of ploughing. It makes it possible to obtain a plating in 25 seconds (disinfection + sample intake + plating).
Traceability ensured with dataLink
All the sample data, from plating (volume, dilution, plating mode ...) to automatic colony counting (lighting settings) are set on the Datamatrix label.


Applications
easySpiral Dilute platers are used for all types of microbiological analyses in the food, pharmaceutical, cosmetic and public research institutes ...
EasySpiral Range Brochure EasySpiral Pro Dilute Technical File